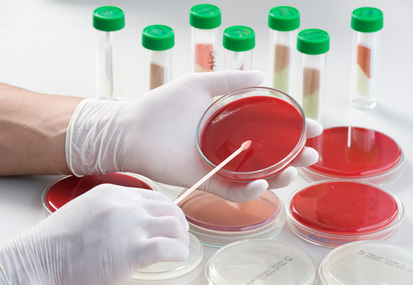
Fritz Schaudinn y Erich Hoffmann

-
Es el primero en observar "animálculos" Bacterias
-
Fue el primero en el que reforzó la teoría de la generación espontanea de gusanos
-
Responsable de crear la primera vacuna contra la Viruela Humana
-
Realiza el primer estudio epidemiologico
-
Refuta la teoría de la generación espontanea de gusanos
-
Descubre el Mycobacterium tuberculosis
-
Coloca una vacuna contra la Rabia.
-
Descubre Escherichia coli.
-
Introduce el uso de las placas Petri a los laboratorios de microbiología.
-
Demuestran que el Treponema pallidum es el agente productor de la sífilis
-
Aísla la penicilina de un cultivo de Penicillium notatum
-
Desarrolla el microscopio de contraste
-
Logra inventar el microscopio electronico
-
Llevan a cabo el aislamiento e identificación del virus del sida.
-
Se descubre la primera bacteria gigante.
-
Se descubre y aparece la gripe Aviar por el sub tipo H5N1
-
Se secuencia el genoma del Saccharopolyspora erythraea, el microorganismo
-
Se descubre un nuevo sub tipo de gripe denominada "Gripe Porcina" por el virus H1N1
-
En Japón se descubre el virus Sars-Cov2 y actualmente se sigue investigando y combatiendo
-
Microbiología Sección B
Looking for a timeline maker?
Create timelines for projects, roadmaps, history, lessons, legal cases, and stories with Timetoast. Timetoast is a timeline maker for work, school, research, and stories.